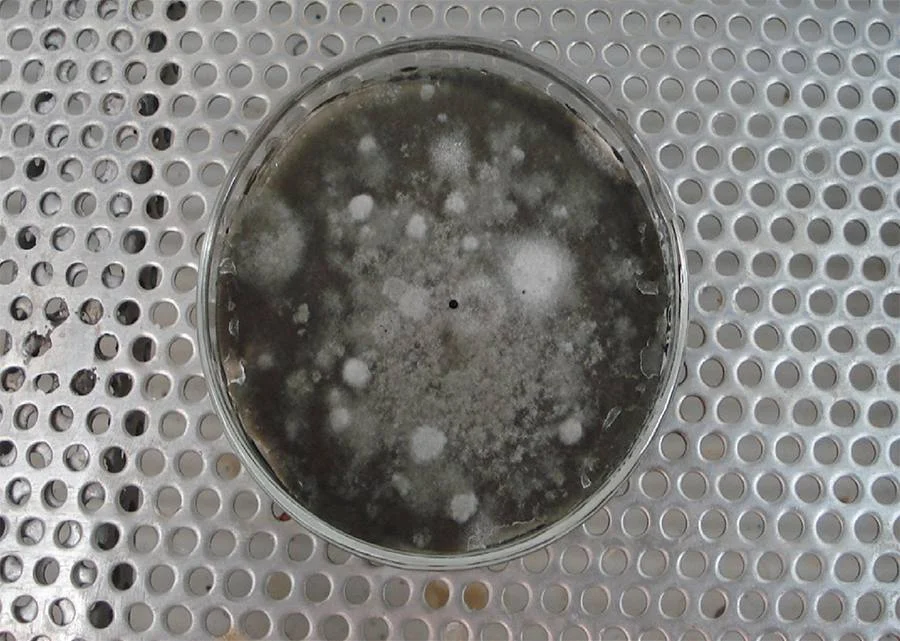
Close-up do fungo Corynespora cassiicola, causador da mancha-alvo, crescendo em uma placa de Petri.

A cotonicultura brasileira vive um momento histórico. Safra após safra, o país tem consolidado sua posição como uma potência global, não apenas em volume de produção, mas também como o líder mundial na exportação da fibra.
Esse sucesso é fruto de um setor que investe em tecnologia, sustentabilidade e, acima de tudo, na busca incessante por qualidade.
Contudo, enquanto o mercado internacional reconhece a excelência do algodão brasileiro, uma ameaça agressiva avança pelas lavouras, colocando em risco essa liderança: a mancha-alvo.
Neste conteúdo, vamos analisar a fundo o avanço da mancha-alvo no algodão nas últimas safras, quantificar seu impacto econômico real e como um manejo proativo e poderoso é fundamental não apenas para proteger a sua lavoura.
Leia também: Do algodão à moda: o potencial da indústria brasileira
O avanço da mancha-alvo: entenda a ameaça que pressiona a cotonicultura
Para construir uma defesa eficaz, o primeiro passo é conhecer o inimigo. A mancha-alvo não é uma doença nova, mas sua ascensão a um dos principais desafios fitossanitários da cotonicultura é um fenômeno recente e preocupante.
A doença, antes secundária, emergiu como uma das principais ameaças da cultura, expandindo-se pelas principais regiões produtoras de algodão e causando perdas cada vez mais expressivas.

Porque a pressão da mancha-alvo no algodão está aumentando nas últimas safras?
O avanço da mancha-alvo não se deu por acaso. Ele é alimentado por uma combinação de fatores que criam o ambiente ideal para o desenvolvimento do fungo.
Condições de alta umidade relativa do ar (acima de 80%), longos períodos de molhamento foliar e temperaturas elevadas são o gatilho para a infecção e a disseminação da doença, fatores esses que são intensificados por práticas agronômicas modernas.
O plantio adensado e os espaçamentos mais curtos, embora visem maior produtividade, criam um microclima úmido e com pouca circulação de ar no interior do dossel da planta, transformando o “baixeiro” em um verdadeiro incubador para o patógeno.
Mais do que isso, a ameaça da mancha-alvo também é uma consequência sistêmica do modelo de produção adotado no Brasil. O fungo causador da doença, o Corynespora cassiicola, é polífago, capaz de infectar mais de 400 espécies de plantas.
No Brasil, o sistema de sucessão soja-algodão é uma realidade em diversas regiões produtoras e tem favorecido o aumento da pressão da doença no campo.
Identificação no campo: como reconhecer a mancha-alvo no algodão?
O reconhecimento precoce dos sintomas da mancha-alvo é crucial para um manejo bem-sucedido. A infecção por Corynespora cassiicola geralmente começa de forma discreta, nas folhas do terço inferior da planta, o chamado “baixeiro”, especialmente após o fechamento das entrelinhas.
Os sinais iniciais incluem lesões circulares de coloração castanho-clara a escura, que se desenvolvem em anéis concêntricos, assemelhando-se a um alvo.

Com a progressão da doença, as manchas podem se unir, necrosando grandes áreas da folha e levando à desfolha precoce do algodão, o que impacta negativamente a produtividade da cultura.
Estudos da Embrapa (Empresa Brasileira de Pesquisa Agropecuária) apontam para perdas de produtividade que podem chegar a 40% em lavouras severamente afetadas.
A desfolha prematura também leva a um enchimento inadequado da fibra. Isso impacta diretamente os parâmetros de qualidade que definem o valor do algodão no mercado, como comprimento, resistência e micronaire.
Além disso, segundo Márcio Portocarrero, Diretor Executivo da Associação Brasileira dos Produtores de Algodão (ABRAPA), a mancha-alvo, junto com a ramulária, tem elevado os custos de produção em até 40%, o que representa uma perda de aproximadamente 4 bilhões de reais a cada safra.
Somados, esses danos diretos e indiretos da mancha-alvo no algodão têm preocupado produtores, que estão em busca de uma estratégia de manejo que seja excepcionalmente poderosa e de ação prolongada desde as primeiras aplicações.
MIRAVIS® Duo: a resposta para um controle simplesmente poderoso da mancha-alvo no algodão
Diante do desafio complexo e de alto risco que o manejo da mancha-alvo impõe para o cultivo do algodão, MIRAVIS® Duo se posiciona como uma solução simples para o produtor e poderosa contra as doenças.
Leia também: Dia mundial do algodão: celebrando inovação e responsabilidade
Uma dupla imbatível: a sinergia entre ADEPIDYN® technology e difenoconazol
A força de MIRAVIS® Duo reside na combinação inteligente e sinérgica de dois ingredientes ativos de alta performance, que atuam de maneiras distintas e complementares para entregar um controle superior: ADEPIDYN® technology e difenoconazol.
ADEPIDYN® technology
O coração de MIRAVIS® Duo é ADEPIDYN® technology, uma molécula inovadora e exclusiva da Syngenta.
Seu grande diferencial é pertencer a um grupo químico completamente novo, as N-metoxy-pirazol-carboxamidas, sendo a única do mercado com essa característica.
Ao introduzir um modo de ação novo, contra o qual o fungo ainda não possui defesa, a ADEPIDYN® technology proporciona um controle simplesmente poderoso da mancha-alvo no algodão.
Difenoconazol
Complementando a inovação da ADEPIDYN® technology, MIRAVIS® Duo ainda conta com o difenoconazol, um triazol consagrado e reconhecido no mercado por sua ação sistêmica e seu amplo espectro de controle.
Sua presença na formulação adiciona um segundo modo de ação, uma prática fundamental para o manejo duradouro e eficaz da mancha-alvo no algodão, ampliando ainda mais a proteção do algodão contra diversas doenças.
Os diferenciais de MIRAVIS® Duo na prática: poder, residual e amplo espectro em ação
A tecnologia de ponta de MIRAVIS® Duo se traduz em benefícios tangíveis, que otimizam o manejo e protegem o investimento do produtor.
- Poder: MIRAVIS® Duo oferece uma alta atividade intrínseca de controle que paralisa o avanço das doenças na lavoura e protege o potencial produtivo da lavoura.
- Residual: MIRAVIS® Duo entrega uma janela de proteção estendida graças ao seu longo residual, com maior segurança, mesmo em períodos chuvosos, e mais flexibilidade operacional para o produtor.
- Amplo espectro: a eficácia de MIRAVIS® Duo vai além da mancha-alvo. Com registro para mais de 40 patógenos, ele oferece controle sobre outras doenças prejudiciais para o algodoeiro, como a ramulária (Ramularia areola), a antracnose (Colletotrichum gossypii), a mancha-de-alternária (Alternaria alternata), a mancha-de-mirotécio (Myrothecium roridum) e a mancha-de-cercóspora (Cercospora gossypina).
- Multicrop: além do algodão, MIRAVIS® Duo oferece uma excelente performance para soja e milho.
Mais que um fungicida, um investimento estratégico para a lavoura
A decisão de adotar uma nova tecnologia no campo é sempre uma análise de custo-benefício. Investir em uma solução de excelência, como MIRAVIS® Duo, não é só uma decisão técnica, mas também econômica: é o que viabiliza maior produtividade, fibras de qualidade superior e competitividade para o algodão brasileiro no mercado internacional.
MIRAVIS® Duo: simples para o produtor, poderoso contra as doenças
A liderança do algodão brasileiro no cenário mundial é um fato, mas ela é desafiada diariamente por ameaças internas como a mancha-alvo. Manter-se no topo exige visão estratégica e adoção das melhores tecnologias disponíveis.
MIRAVIS® Duo se apresenta como a resposta para esse desafio. É uma ferramenta que combina o poder de uma formulação inovadora com a simplicidade de um manejo eficiente, oferecendo proteção de amplo espectro e longo residual, que blindam a lavoura e a rentabilidade do produtor.
Investir em um manejo de excelência é a chave para a competitividade. Com MIRAVIS® Duo, a proteção da sua lavoura se torna simples para o produtor e poderosa contra as doenças.
A Syngenta está ao lado do produtor rural em todos os momentos, oferecendo as soluções necessárias para construirmos, juntos, um agro cada vez mais inovador, rentável e sustentável.
Confira a central de conteúdos Mais Agro para ficar por dentro de tudo o que está acontecendo no campo.





Deixe um comentário